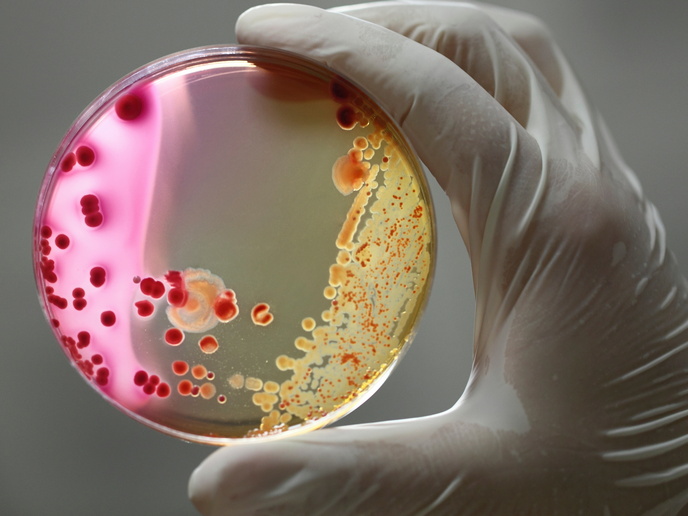

Microrrobots que imitan funciones biológicas
Una propiedad fascinante de los seres vivos es que su movimiento puede ser guiado por estímulos químicos, un fenómeno denominado «quimiotaxis». «Gracias a la quimiotaxis, las células pueden moverse hacia un atrayente químico o alejarse de un repelente químico –explica Larisa Florea, coordinadora del proyecto ChemLife(se abrirá en una nueva ventana) en el Trinity College de Dublín(se abrirá en una nueva ventana) –. Este proceso es fundamental para muchas funciones biológicas, como la evasión de toxinas por parte de las bacterias o el desplazamiento de las células inmunitarias al lugar de una infección».
Vehículos sensoriales microestructurados
El objetivo del proyecto ChemLife, financiado por el Consejo Europeo de Investigación(se abrirá en una nueva ventana), era imitar sintéticamente la quimiotaxis a microescala. «Los seres vivos son mucho más complejos que los materiales artificiales —agrega Florea—, pero es posible que, combinando la química, el diseño inteligente y la fabricación tridimensional precisa, podamos lograr capacidades mejoradas en materiales blandos». La idea de Florea era crear vehículos microestructurados. Estos sistemas podrían «navegar» a través de entornos fluidos complejos y «reconocer» o «detectar» eficazmente rastros químicos concretos. «El primer tipo de vehículos que desarrollamos era muy, muy simples, gotículas —comenta Florea—. Al pensar en microvehículos, a algunos nos vienen a la cabeza películas como “Viaje alucinante”. Pero en ChemLife logramos demostrar que las gotículas con un volumen de microlitro pueden seguir gradientes químicos a lo largo de grandes distancias, al igual que las bacterias buscan alimento». En el proyecto también se demostró que estas gotículas «inteligentes» pueden moverse impulsadas por gradientes de tensión superficial, localizar fuentes de quimioatrayentes en redes de fluidos complejas e incluso detectar y comunicar información sobre su entorno local durante su recorrido. «Puede que no sea el microrobot que imaginamos, pero es uno», afirma Florea.
Microestructuras poliméricas tridimensionales complejas
El siguiente objetivo fue pasar de las gotículas a microestructuras poliméricas tridimensionales más complejas. «Creamos una variedad de polímeros sensibles a estímulos con funcionalidades específicas —explica Florea—. Entre estos se incluían micropalancas que se doblan bajo estimulación eléctrica, microflores que se abren en respuesta a señales químicas y microestructuras que cambian de color dependiendo del entorno químico local». Esta investigación pionera ha dado lugar a diferentes descubrimientos. «Poder controlar estos robots líquidos con campos eléctricos fue un momento Eureka para nosotros —comenta Florea—. Asimismo, una de nuestras brillantes doctoradas, Annael Sort-Montenegro, demostró, hasta donde sabemos, los electroactuadores de hidrogel más rápidos jamás creados». Este trabajo dio lugar al desarrollo de una caja de herramientas biomiméticas: una biblioteca de vehículos adaptables para una amplia variedad de supuestos. «La integración de estos microvehículos en sociedades “inteligentes” capaces de hacer tareas complejas supondría un logro muy emocionante —comenta Florea—. Siempre tenemos que pensar en aplicaciones en entornos que son de difícil acceso, donde hay objetos micrométricos tan pequeños que no se pueden ver a simple vista».
Neurocirugía y administración localizada de fármacos
Entre sus posibles aplicaciones finales se encuentra la neurocirugía, donde la manipulación remota de estos microrrobots podría ayudar a navegar por la compleja red de arterias del organismo. Jason Delente, colaborador de Florea, es pionero en este campo. Otras aplicaciones potenciales incluyen la administración localizada a demanda de fármacos. Aunque el camino hacia la aplicación no siempre es sencillo, los avances logrados en este proyecto están sirviendo de base para desarrollos posteriores. «Recientemente exploramos algunas de las químicas desarrolladas en ChemLife para crear implantes ajustables», concluye Florea. «Del mismo modo, estamos utilizando el hecho de que podemos fabricar microestructuras reactivas con una precisión exquisita en otro proyecto europeo, IV-Lab, para crear sensores químicos y bioquímicos tan pequeños que puedan implantarse en venas o arterias».